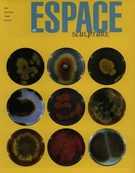
Cover of Art public, Number 48, Summer 1999, pp. 5-48, Espace Sculpture

ÉvénementsEvents
Georges DyensDans la tourmente[Record]
- Isabelle Riendeau
Online publication: Feb. 26, 2010
A review of the journal Espace Sculpture
This article is a review of another work such as a book or a film. The original work discussed here is not available on this platform.
Number 48, Summer 1999, p. 41–42
Art public
Tous droits réservés © Le Centre de diffusion 3D, 1999